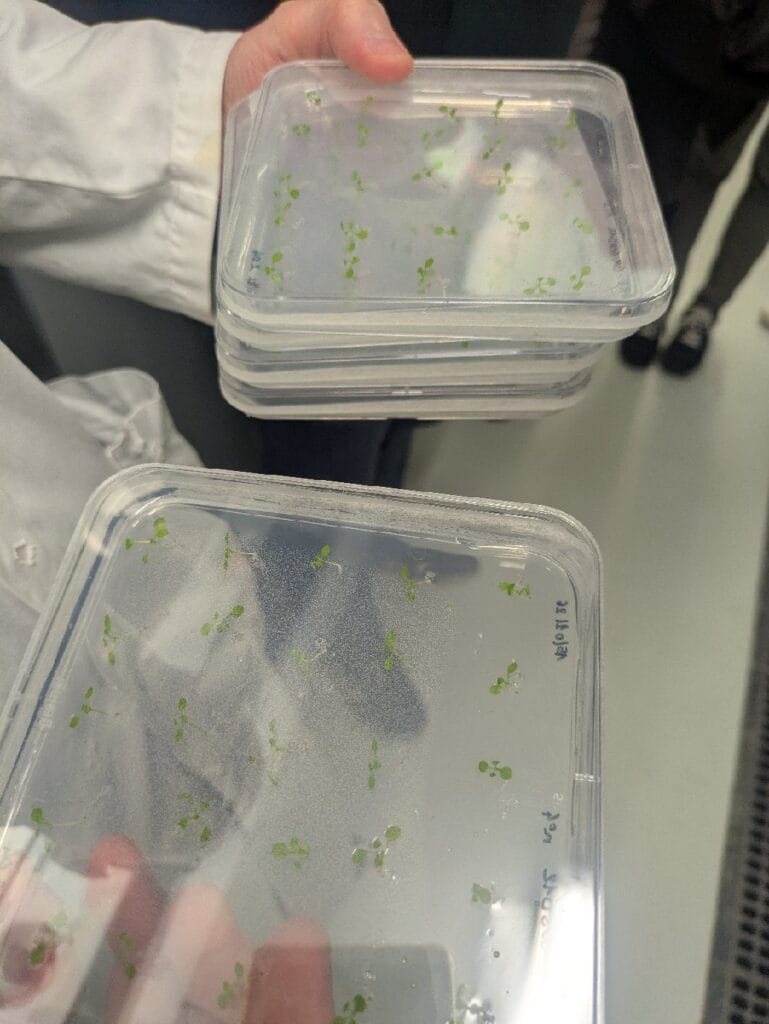
Sortie « Des Plantes et des Hommes » avec des élèves de spécialité SVT en terminale 5 visite 2

Des élèves de spécialité SVT en terminale ont eu la chance de se rendre sur le site de l’Institut des Sciences des Plantes de Paris-Saclay (IPS2) pour participer au programme de médiation scientifique « Des Plantes et des Hommes ».
Lors de la sortie, les élèves ont participé à plusieurs activités :
- un atelier interactif et ludique qui aborde l’histoire de la domestication et de la sélection des plantes, ainsi que l’évolution des pratiques culturales en lien avec la génétique végétale et le développement durable. Les élèves se sont bien prêtés au jeu et ont appris de nombreuses anecdotes sur l’histoire de la domestication des plantes.



- une présentation des métiers de la recherche et une visite des laboratoires et des serres de l’IPS2 par un enseignant chercheur. L’occasion pour les élèves de mieux comprendre les études universitaires et le quotidien d’ un chercheur scientifique.

Nina Michel-Lauret, enseignante en SVT